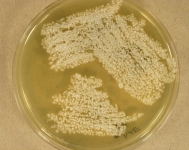

<< back to search
IMAGES:



































Search Details
add to cart
| UAMH Number: | 11532 |
|---|---|
| Species Name: | Aspergillus caninus |
| Type: | |
| Synonyms: | Phialosimplex caninus |
| Taxonomy: | FUNGI Ascomycota, Eurotiomycetes, Eurotiales, Aspergillaceae |
| Strain History: | Hanselman, B. (52085) -> UAMH |
| Substrate: | swab and tissue, lymph node repeat specimen, 7 yr old female spayed miniature poodle with abdominal masses; cytology + variable sized yeast cells and sparse hyphae and yeast-like cells; treated with itraconazole | Location: | CANADA Ontario, Oakville, Mississauga Oakville Veterinary Emergency Hospital (GEO: 43.516,-79.674) |
| Isolator: | (I) L. Sigler; (C) B. Hanselman, DVM |
| Isolation Date: | 2011-06-17 |
| Date Received: | 2011-06-22 |
| Characters: | CULTURE CONDITIONS grows @ 30 C but more slowly @ 35 C - fide UAMH 2011 // CYCLOHEXIMIDE sensitive (no growth MYC) - fide UAMH 2011 // HUMAN/ ANIMAL PATHOGEN repeat specimen grew heavy growth of Phialosimplex caninus in pure culture from swab and tissue specimen - fide UAMH 2011 // MOLECULAR SYSTEMATICS ITS 100% similarity to UAMH 11502 - fide UAMH 2012 (Click for publications citing UAMH 11532) |
| Compounds: | |
| Cross Reference: | UAMH 11502 |
| Collections: | Living Strains; Dried Herbarium Material |
| Pathogenic Potential: | Human: yes | Animal: yes | Plant: no |
| Biosafety Risk Group: | RG2 (check the PHAC ePATHogen Risk Group Database for updates) |
| Regulatory Requirements: | Canadian requesters must provide PHAC Pathogen and Toxin License Number (see: https://www.canada.ca/en/public-health/services/laboratory-biosafety-biosecurity/licensing-program.html) prior to shipment. International requesters must provide all legally required importation documentation prior to shipment. Plant pathogenicity status may be verified by using the USDA Agricultural Research Service (ARS) Fungal Database |
| MycoBank ID: | 809580 |
IMAGES: